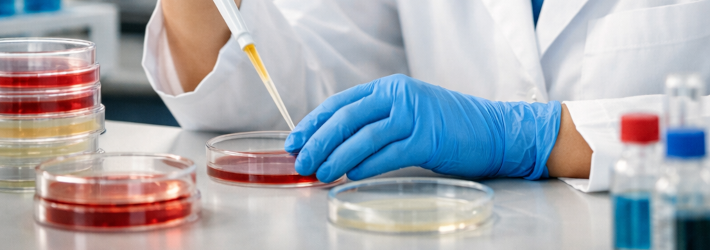

On March 9, 2026, the FDA updated its guidance addressing biosimilar development under the Biologics Price Competition and Innovation Act (BPCIA) (“New and Revised Draft Q&As on Biosimilar Development and the BPCI Act (Revision 4)”). These updates follow the FDA’s earlier announcements in October 2025 which removed the requirements of comparative efficacy studies to demonstrate biosimilarity and switching studies to demonstrate interchangeability in many circumstances (previously reported FDA Moves to Accelerate Biosimilar Development and Lower Drug Costs in New Draft Guidance).
Traditionally, biosimilar developers have been expected to conduct at least one clinical pharmacokinetic (PK) study directly comparing the proposed biosimilar to the U.S.-licensed reference product. In addition, where sponsors relied on data generated using a non-U.S.-licensed comparator product, the FDA generally recommended a three-way PK study bridging the proposed biosimilar, the U.S.-licensed reference product, and the foreign comparator.
Under the revised draft guidance, the FDA indicates that such studies may not be necessary in all cases. Where scientifically justified, applicants may be able to rely on clinical data with a non-U.S.-licensed product without conducting a three-way PK study. The FDA also removed the recommendation that every biosimilar application include a PK study directly comparing the proposed product with the U.S.-licensed reference product.
In addition, the FDA finalized its previously issued “New and Revised Draft Q&As on Biosimilar Development and the BPCI Act (Revision 3)” (September 2021), withdrawing and updating Q&As I.8, I.10, and I.19.
The FDA also withdrew the 2015 final version of the scientific considerations guidance “Scientific Considerations in Demonstrating Biosimilarity to a Reference Product” due to changes in FDA’s current thinking.
For more information about biosimilars and biosimilar patent disputes, please visit BiologicsHQ.
_____________________________________________________
The authors would like to thank April Breyer Menon for her contributions to this article.